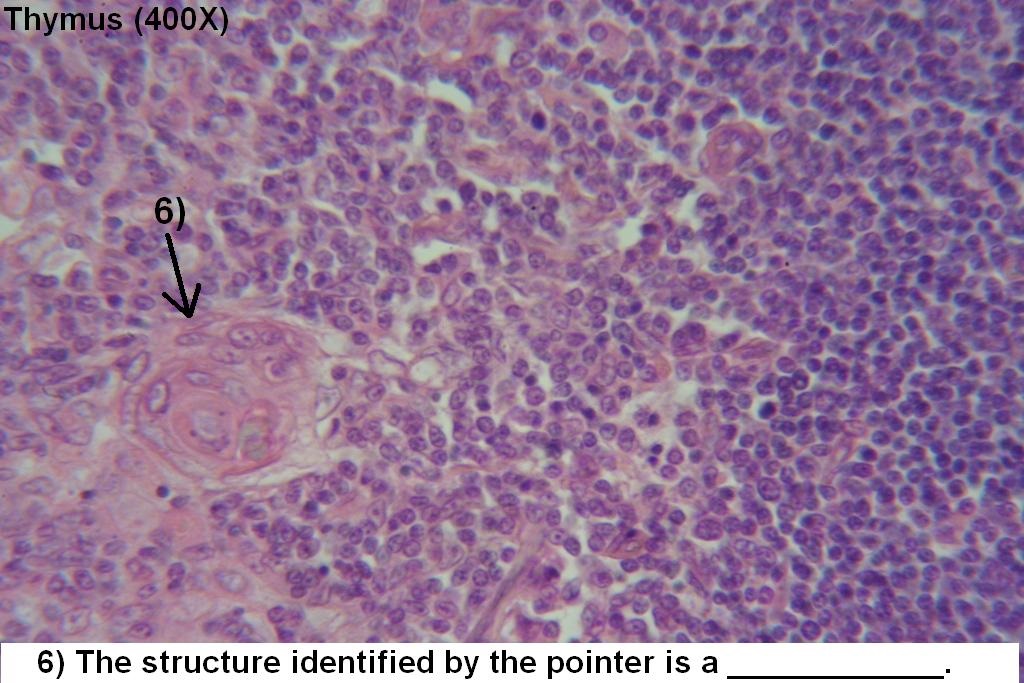

- Teacher: JOEY ASUNCION
- Teacher: VANESSA MAE MOSCOSO

- Teacher: JOEY ASUNCION
- Teacher: VANESSA MAE MOSCOSO
- Teacher: JOEY ASUNCION
- Teacher: VANESSA MAE MOSCOSO

- Teacher: JOEY ASUNCION
- Teacher: DARYLLE JOI GOMEZ

- Teacher: JOEY ASUNCION
- Teacher: DARYLLE JOI GOMEZ

- Teacher: JOEY ASUNCION
- Teacher: DARYLLE JOI GOMEZ